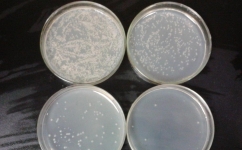
forum forum

在当今竞争激烈的市场环境中,品牌产品营销对于企业的成功至关重要。对于培养基品牌而言,制定有效的营销策略以提高产品知名度、吸引潜在客户并保持现有客户的忠诚度显得尤为重要。本文将深入探讨如何为培养基品牌制定有效的产品营销策略,并通过实例进行说明。
1. 明确目标市场和客户群体
首先,企业需要明确目标市场和客户群体。培养基品牌的潜在客户可能包括生物技术公司、制药企业、研究机构、医疗机构等。通过对这些客户的需求进行深入了解,企业可以更好地满足他们的需求,从而提高产品的吸引力。
例如,Thermo Fisher Scientific(赛默飞世尔科技)是一家生物技术产品供应商,其产品包括各种类型的培养基。该公司通过与客户保持紧密联系,了解客户的需求并提供满足这些需求的产品。
2. 确立品牌定位和价值主张
品牌定位是企业在目标市场中与竞争对手区分开来的关键。培养基品牌可以根据产品质量、价格、创新程度、服务等因素来确定品牌定位。此外,企业还需要明确价值主张,即企业为客户提供的独特价值。这可以帮助企业在市场中脱颖而出,吸引潜在客户。
例如,Sigma-Aldrich(赛格玛-奥德里奇)是一家提供高质量培养基的公司。该公司的品牌定位是提供高质量、高性能的产品,其价值主张是帮助客户提高实验效率和成功率。
3. 制定营销策略
在明确目标市场、客户群体、品牌定位和价值主张后,企业需要制定相应的营销策略。这可能包括以下几个方面:
(1) 产品策略:企业需要根据目标市场和客户需求,开发具有竞争力的培养基产品。这可能包括提高产品质量、降低成本、开发新型培养基等。
(2) 价格策略:企业需要根据品牌定位和目标客户的消费能力,制定合适的价格策略。这可能包括采用高价策略、低价策略或差异化价格策略。
(3) 渠道策略:企业需要选择合适的销售渠道,以便将产品快速、有效地推向市场。这可能包括建立自有销售网络、与代理商合作、开展电子商务等。
(4) 促销策略:企业需要通过各种促销活动,提高产品知名度并刺激销售。这可能包括举办展览会、发布广告、开展公关活动、提供试用装等。
例如,BD(贝克顿-迪金森公司)是一家生物技术产品供应商,其产品包括各种类型的培养基。该公司通过与代理商合作,将产品推向全球市场,并通过参加展览会、发布广告等方式提高产品知名度。
4. 营销传播
为了提高培养基品牌的知名度,企业需要通过各种渠道进行营销传播。这可能包括:
(1) 线上渠道:企业可以通过建立官方网站、开展网络广告、运营社交媒体账号等方式,向潜在客户传递品牌信息。
(2) 线下渠道:企业可以通过参加展览会、举办研讨会、发布印刷广告等方式,扩大品牌影响力。
(3) 合作伙伴:企业可以与行业组织、研究机构、代理商等合作伙伴建立合作关系,共同推广培养基品牌。
例如,Corning(康宁公司)是一家生物技术产品供应商,其产品包括各种类型的培养基。该公司通过与全球各地的代理商合作,扩大品牌影响力,并通过参加展览会、举办研讨会等方式与潜在客户建立联系。
总之,对于培养基品牌而言,制定有效的产品营销策略至关重要。企业需要明确目标市场和客户群体、确立品牌定位和价值主张、制定营销策略并通过各种渠道进行营销传播。通过这些策略,企业可以提高产品知名度、吸引潜在客户并保持现有客户的忠诚度。 |